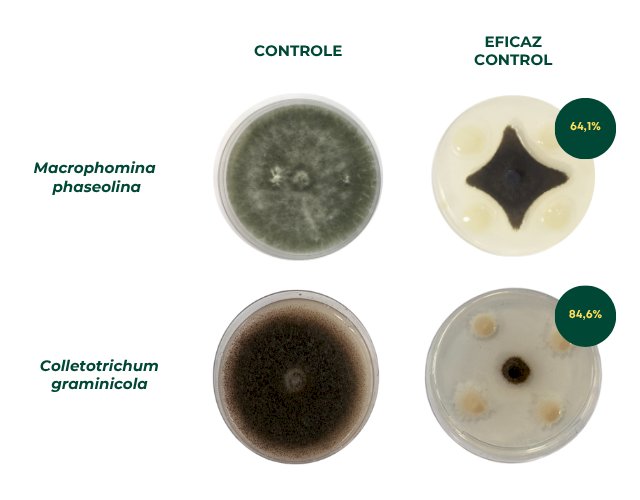

Novo biofungicida controla fungos de solo com elevada eficiência
Por Sandra Brito, Embrapa Milho e Sorgo
Uma bactéria encontrada no Cerrado pode fortaceler o combate a fungos no solo. Desenvolvido pela Embrapa em parceria com a empresa Simbiose, o biofungicida Eficaz Control é o primeiro do mercado brasileiro a usar uma cepa da bactéria Paenibacillus ottowii como agente de controle biológico. O microrganismo e a sua ação antifúngica foram identificados pela Embrapa Milho e Sorgo (MG). A nova tecnologia combate até 80% da infestação de patógenos que causam podridão de raízes e caules em lavouras de milho, soja e outras culturas.
Foto: Fernando Tavares Fernandes (podridão por Fusarium spp)
O produto apresentou ação comprovada em campo no controle de infestação de patógenos como Fusarium spp., Macrophomina phaseolina e Colletotrichum graminicola — responsáveis por doenças que causam podridão de raízes e colmos. O Eficaz Control já está registrado para uso em lavouras de milho e soja contra Fusarium spp. e deve, em breve, ser liberado para combater os demais fungos. A nova tecnologia oferece aos produtores uma alternativa viável, segura e eficaz para substituir fungicidas químicos, especialmente no tratamento de sementes e aplicação no sulco de semeadura.
Aliado à cepa de microrganismo da espécie Paenibacillus ottowii, o Eficaz Control traz também uma cepa de Bacillus velezensis. Ambas se destacaram nos testes iniciados em 2016, pelas equipes de Microbiologia e Fitopatologia da Embrapa Milho e Sorgo, em um criterioso processo de isolamento e seleção de microrganismos.
“O produto é resultado de mais de nove anos de pesquisa e envolveu avaliação e teste de 190 microrganismos provenientes de estigmas de milho e de sementes de sorgo,” frisa a pesquisadora Christiane Abreu de Oliveira Paiva, ao contar que além controlar os fungos, as duas cepas selecionadas promoveram também o aumento da produtividade do milho e da soja. Ambas foram coletadas no bioma Cerrado, no município mineiro de Sete Lagoas.
Por meio de um acordo de cooperação técnica, as cepas foram transferidas da Embrapa para a Simbiose, a qual desenvolveu a formulação ideal para compor o biofungicida, que foi submetido a testes de campo em larga escala e recebeu o nome comercial de Eficaz Control.
“O uso combinado de microrganismos com diferentes mecanismos de ação reduz a pressão seletiva sobre o Fusarium, pois retarda o surgimento de resistência e garante um controle mais eficaz e estável ao longo das safras e diferentes condições ambientais”, detalha o pesquisador da Embrapa Luciano Viana Cota.
Fotos: divulgação
Uma alternativa real aos químicos
Artur Soares, diretor de Pesquisa e Desenvolvimento da Simbiose relata que foram realizados estudos em campo em todo o Brasil, desde 2020, para desenvolver o biofungicida. “Em todos os testes, o novo fungicida biológico superou a performance dos químicos em controle de doenças, prevenção de perdas e ganho de produtividade. Os resultados reforçaram nossa confiança na performance da tecnologia”, informa o diretor.
Marcelo de Godoy Oliveira, CEO do ecossistema Cogny, do qual a Simbiose faz parte, conta que um marco importante é o registro do Eficaz Control. Diferentemente dos fungicidas químicos, que dependem do registro junto ao Ministério da Agricultura para a aplicação em cada tipo de cultura, o insumo biológico da Simbiose pode ser usado na cobertura de todas as culturas afetadas por essas doenças fúngicas.
“Hoje temos 40 milhões de hectares de soja no Brasil tratados com insumos químicos e apenas 1,5 milhão de hectares com biológicos. Por força dos benefícios, o Eficaz Control aumentará a competitividade da Simbiose no mercado, como o segmento de soja, por exemplo, o qual movimenta hoje mais de R$ 400 milhões por ano em fungicidas”, aposta Oliveira.
O executivo informa que, atualmente, cinco multinacionais dominam mais da metade do mercado brasileiro. “O Eficaz Control chega para difundir a cultura do microbiológico para mais produtores e também para democratizar o mercado agrícola. Temos hoje no Brasil uma indústria de biológicos que merece espaço para ser mais competitiva, já que pode produzir localmente com qualidade e rigor técnico”, defende Oliveira.
Avanço no controle das podridões
O Eficaz Control é aplicado uma única vez no tratamento de sementes para o plantio protegendo as plântulas nos estádios iniciais de desenvolvimento, garantindo a formação de um stand adequado e menor custo de aplicação e baixo impacto ambiental em virtude da menor dose aplicada do produto.

Esse é um fator importante, porque a infestação por esses fungos pode não ser percebida pelo produtor e a aplicação de fungicida químico pode não ser suficiente para prevenir os danos. E quando os sintomas aparecem, a situação já está grave, causando tombamento das plantas.
“O Eficaz Control é inovador, pois, apresenta elevada eficiência no controle dos fungos de solo quando aplicado diretamente nas sementes. O que é um diferencial em relação às principais medidas que existiam até agora para o controle de patogenos, como a resistência genética, o controle químico e a rotação de culturas”, frisa o pesquisador da Embrapa Rodrigo Véras. “Hoje, na cultura do milho, os fungos de solo, causadores da podridão de raiz e do colmo são os grupos de patógenos mais difíceis de trabalhar e também os que têm alto potencial de gerar perdas e danos às lavouras”, pontua.
Véras conta ainda que a resistência genética é difícil de ser desenvolvida para um grupo muito grande de patógenos e o trabalho para o desenvolvimento de técnicas de fenotipagem que permitam desenvolver cultivares resistentes é muito difícil. Esses desafios tornam o melhoramento genético voltado para o controle dos fungos de solo bem complexo. Outro ponto, é a dificuldade de realizar o controle químico uma vez que esses fungos ficam em uma região de difícil acesso no solo ou na raiz. Além disso, o pesquisador explica que, para esse grupo de fungos, a rotação de culturas pode não ser muito eficiente.
Fotos: Acervo pessoal (bolsista da Embrapa Gisele de Fátima Dias Diniz analisa planta), Rodrigo Veras e divulgação
O chefe-adjunto de Transferência de Tecnologias em exercício da Embrapa Milho e Sorgo, Alexandre Ferreira da Silva, considera que as parcerias com a iniciativa privada são essenciais para acelerar o desenvolvimento e a disseminação de bioinsumos no setor agrícola. “A importância desses insumos biológicos é inquestionável para a sustentabilidade e produtividade da nossa agricultura. Eles representam um salto, oferecendo soluções mais seguras e amigáveis ao meio ambiente para controle de pragas, doenças e melhoria da saúde do solo”, declara Silva.
A equipe de pesquisa
A equipe da Embrapa Milho e Sorgo que participou do desenvolvimento do Eficaz Control é composta por Christiane Abreu de Oliveira Paiva, Luciano Viana Cota, Rodrigo Véras da Costa , Dagma Dionísia da Silva Araújo, Maria Lúcia Ferreira Simeone, Sylvia Morais Sousa Tinoco, José Edson Fontes Figueiredo, Ubiraci Gomes de Paula Lana, Ivanildo Evodio Marriel, Eliane Aparecida Gomes, Maycon Campos Oliveira, Paulo Eduardo França de Macedo, Reinaldo Vasco Junior e Denio Alves de Deus e pela bolsista de doutorado Gisele Diniz. Participaram também, da Embrapa Pesca e Aquicultura, o pesquisador Rodrigo Estevam Munhoz de Almeida e as bolsistas Agnelia Luiza Pereira da Costa, Maria Cistina Kalil Rocha e Micaele Rodrigues de Souza.
Jornada Pelo Clima – a Embrapa na COP 30O Brasil está consolidado entre os líderes mundiais em produção de bioinsumos agrícolas e esses produtos são estratégicos para o manejo integrado de pragas (MIP). A Embrapa desenvolve e promove pesquisas e transferência de tecnologias e conhecimentos que contribuem para adaptar as boas práticas agropecuárias, aumentando a sustentabilidade e garantindo a segurança alimentar e nutricional. Essas tecnologias serão destacadas pela Embrapa durante os eventos da Jornada Pelo Clima na Conferência das Nações Unidas sobre Mudanças Climáticas (COP30), que ocorrerá de 10 a 21 de novembro, em Belém (PA). O Programa Nacional de Bioinsumos, bem como o Conselho Estratégico do Programa Nacional de Bioinsumos, foram instituídos pelo Decreto No 10.375, de 26 de maio de 2020. O objetivo é, sobretudo, reduzir a dependência de insumos importados e alavancar, de forma sustentável, o uso do potencial da biodiversidade do Brasil. |
Trabalho contribuiu para a formação de pessoalOs testes com as duas cepas avaliaram a capacidade de inibir os fungos fitopatogênicos, como o Fusarium spp, e sua habilidade de promover o crescimento vegetal. Vários dados obtidos com os testes destas cepas na inibição dos fungos fizeram parte da dissertação de mestrado e da tese de doutorado da especialista em Microbiologia, Gisele de Fátima Dias Diniz, bolsista da Embrapa Milho e Sorgo. |
Lançamento no Congresso da AndavO lançamento do Eficaz Control acontecerá no dia 5 de agosto durante o Congresso da Associação Nacional dos Distribuidores de Insumos Agrícolas e Veterinários (Andav) Andav, no Transamérica ExpoCenter, em São Paulo. O evento acontece de 5 a 7 de agosto e reunirá especialistas e líderes do setor de agronegócios. Transamérica ExpoCenter: Av. Dr. Mário Villas Boas Rodrigues, 387 – Santo Amaro, São Paulo (SP). |









